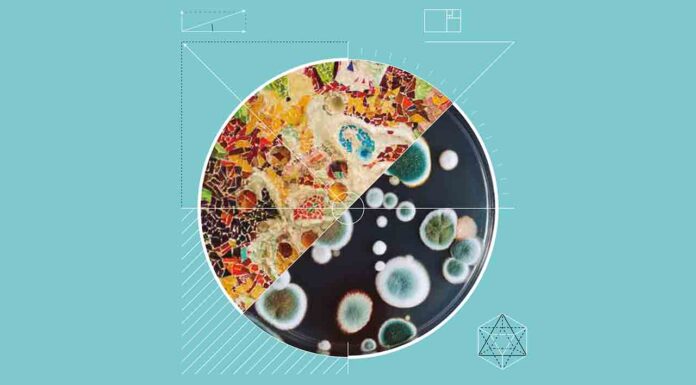
Barcelona celebrará la segunda edición de la Bienal Ciudad y Ciencia Barcelona celebrará la segunda edición de la Bienal Ciudad y Ciencia entre el 8 y el 13 de junio

Actualidad: Eventos
El Festival Cruïlla comienza el 8 de julio con 25.000 test diarios
El Festival Cruïlla volverá al Parc del Fòrum los días 8, 9 y...
La Nit de los Museus atrae a más de 34.000 visitantes
A pesar de ser una edición especial con un horario mucho más reducido y...
Nou Barris reconvierte su Fiesta Mayor en una celebración de la primavera
Nou Barris se vuelve a vestir de fiesta para celebrar la primavera y...
Barcelona Design Week 2021 se celebrará en primavera y en otoño
La Barcelona Design Week 2021 se celebrará con un formato distinto para adaptarse a...
Barcelona celebra el 21 Concurso Internacional de Roses Noves
El Parque de Cervantes acoge el 21º Concurso Internacional de Roses Noves, que se celebra este...
10 marcas innovadoras en la segunda edición del Barcelona Fashion Forward
Hoy ha comenzado la mentoría a las 10 marcas emprendedoras de diseño y moda...
La Feria Audiovisual ISE, calienta motores en la Fira Barcelona
Integrated Systems Europe (ISE) y AVIXA anuncian AV Experience Zone, un evento especial de dos...
Festival de Barcelona Verano GREC 2021
Después de una edición que estuvo marcada por la Covid, el Festival Grec de verano de Barcelona quiere ser...
El servicio VinclesBCN acerca a las personas mayores a los museos
El confinamiento está teniendo un gran impacto psicosocial entre las personas mayores, convirtiéndose en...
Barcelona propone museos gratuitos para los residentes
El Ayuntamiento de Barcelona ha planteado que el acceso a los museos para visitarlas exposiciones permanentes, puedan ser...
El estudio del concierto de Love of Lesbian descarta la transmisión de Covid
Los resultados del estudio del concierto piloto de Love of Lesbian que...
Inauguración de la exposición itinerante 'Relats revelats'
El Archivo Municipal de Barcelona inaugura esta semana una muestra itinerante que expone una parte de los fondos...
Subvenciones para fomentar actividades de música en vivo este verano
Barcelona creará una nueva línea de subvenciones para fomentar la organización de conciertos musicales este...
Mercat de la Nosa y coleccionismo en Hostafrancs
Situado en una de las zonas más comerciales de Barcelona, en el barrio de Hostafrancs del distrito...
Barcelona anhela dar la bienvenida a ISE Live & Online
El director general de Integrated Systems Events, Mike Blackman, ha regresado a Barcelona esta semana...
Se suspende el festival Sónar y queda aplazado hasta el 2022
La organización del festival Sónar considera inviable hacerlo en las condiciones deseables por la...
Segunda edición del Congreso de Competencias Digitales
La segunda edición del Congreso de Competencias Digitales ha reunido hoy expertos para abordar las habilidades y competencias...
Barcelona Fashion Forward impulsará las marcas de moda emergentes en la ciudad
El Ayuntamiento de Barcelona, a través de Barcelona Activa, ha lanzado la segunda...
Irene Vallejo será la Pregonera de la Lectura 2021
El 22 de abril a las 18 horas la escritora Irene Vallejo será la encargada de...
Barcelona celebrará la segunda edición de la Bienal Ciudad y Ciencia entre el 8 y el 13 de junio
La segunda edición de la Bienal...